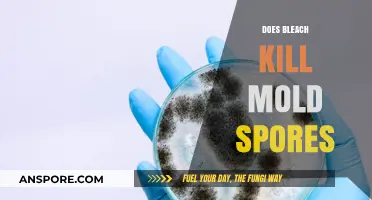
Does Bleach Kill Mold Spores? Uncovering the Truth Behind the Myth

Obtaining jungle spores in various games or contexts often requires a combination of exploration, timing, and strategy. Typically found in lush, dense jungle environments, these spores are usually hidden within specific plants, glowing mushrooms, or scattered across the forest floor. Players or gatherers must navigate through treacherous terrain, avoiding hostile creatures and environmental hazards, while keeping an eye out for telltale signs of spore-bearing flora. Some games may also require tools or specific conditions, such as nighttime or rain, to reveal or harvest the spores effectively. Patience and attention to detail are key, as jungle spores are often rare and valuable resources used for crafting, quests, or enhancing abilities.
| Characteristics | Values |
|---|---|
| Source | Jungle Spores are primarily obtained from the Fungi Cavern in the Jungle biome. |
| Biome | Jungle |
| Location | Underground, within the Fungi Cavern. |
| Required Tools | Hammer or Pickaxe to break spore-bearing blocks (e.g., Mushroom grass, glowing mushrooms). |
| Time | Can be found at any time of day or night. |
| Rarity | Common within the Fungi Cavern. |
| Uses | Crafting (e.g., Mushroom Spears, Plantera's Hook), farming for biomes, and decorative purposes. |
| Additional Notes | Spores spread naturally in the Jungle, but farming in the Fungi Cavern is more efficient. |
Explore related products
What You'll Learn
- Finding Jungle Biomes: Locate dense, green biomes with vines, tall grass, and unique foliage for spore sources
- Identifying Spore Plants: Look for glowing, mushroom-like plants that release spores in dark areas
- Harvesting Techniques: Use shears or tools to carefully collect spores without damaging the plant
- Optimal Time for Collection: Gather spores at night or in shaded areas for higher yields
- Storage and Preservation: Store spores in glass containers away from light to maintain viability

Finding Jungle Biomes: Locate dense, green biomes with vines, tall grass, and unique foliage for spore sources
Dense, green biomes teeming with life are your primary targets when hunting for jungle spores. These biomes, characterized by their lush vegetation, towering trees, and tangled vines, are the natural habitats of spore-producing plants. Unlike other biomes, jungles offer a unique combination of humidity, sunlight, and organic matter that fosters the growth of spore-bearing species. To maximize your chances of success, focus on areas with tall grass, large ferns, and unique foliage like melons or cocoa pods, as these often indicate a thriving ecosystem rich in spore sources.
Locating jungle biomes requires a strategic approach. Start by exploring regions near rivers or coastlines, as jungles often border these water sources. Use in-game maps or mods that highlight biome types if available, but don’t rely solely on technology—train your eye to recognize the distinct visual cues of a jungle. Look for the deep green hues of dense foliage, the swaying motion of tall grass, and the intricate patterns of vines climbing trees. If you’re playing in a version of Minecraft that includes biomes like the "Bamboo Jungle," prioritize these areas, as bamboo itself can sometimes be a spore source or indicator of nearby spore-rich plants.
Once you’ve identified a jungle biome, navigate it methodically to collect spores efficiently. Begin at the edge of the biome and work inward, scanning the ground for patches of mushrooms or other spore-producing plants. Carry a shovel or hoe to harvest these plants without destroying them, ensuring a sustainable yield. Be cautious of jungle-specific dangers, such as ocelots, parrots, or hostile mobs that thrive in dense foliage. Wear armor and bring torches to light your path, reducing the risk of ambush while you focus on spore collection.
Comparing jungle biomes to other spore-rich areas, such as swamps or mushroom fields, highlights their superiority in diversity and density. While swamps may offer giant mushrooms, jungles provide a wider variety of spore sources, including smaller fungi and unique plants. Mushroom fields, though spore-rich, lack the ecological complexity of jungles, making them less sustainable for long-term spore harvesting. By prioritizing jungle biomes, you not only increase your spore yield but also immerse yourself in one of the game’s most vibrant and challenging environments.
Chanterelles' Spore Secrets: Unveiling the Mushroom's Reproduction Mystery
You may want to see also

Identifying Spore Plants: Look for glowing, mushroom-like plants that release spores in dark areas
In the dense, shadowy undergrowth of jungles, bioluminescent plants often thrive, their soft glow a beacon for those seeking jungle spores. These mushroom-like organisms, typically found in areas with minimal sunlight, emit a faint green or blue light that illuminates their spore-releasing structures. To identify them, look for clusters of cap-and-stem formations resembling oversized fungi, often nestled in damp soil or decaying wood. Their glow is not just a visual cue but a survival mechanism, attracting nocturnal creatures that inadvertently disperse their spores.
To maximize your chances of finding these plants, venture into the jungle during twilight or nighttime hours, when their bioluminescence is most pronounced. Equip yourself with a dim red light to preserve your night vision while navigating the terrain. Avoid using bright white lights, as they can diminish the visibility of the plants' natural glow. Focus your search in areas with high humidity, such as near streams or under dense canopy cover, where these plants flourish.
Once you locate a glowing mushroom-like plant, observe its spore release mechanism. Typically, spores are discharged through small openings (ostioles) on the underside of the cap or from the plant's central stalk. Gently disturb the plant with a gloved hand or a soft brush to encourage spore release, but avoid touching the glowing parts directly, as some species may be fragile or mildly toxic. Collect the spores using a clean, dry container with a tight-fitting lid to prevent contamination.
For optimal spore collection, time your expedition during the jungle's wet season, when humidity levels peak and these plants are most active. If you're cultivating spores for personal use, ensure your storage container is airtight and kept in a cool, dark place. Label the container with the collection date and location, as spore viability can vary depending on environmental conditions. With patience and attention to detail, identifying and harvesting jungle spores becomes a rewarding endeavor, blending scientific observation with the thrill of exploration.
Are Fern Spores Harmful to Humans? Uncovering the Truth
You may want to see also

Harvesting Techniques: Use shears or tools to carefully collect spores without damaging the plant
Jungle plants often release spores in delicate, ephemeral bursts, making their collection a task that demands precision and care. Using shears or specialized tools is not just a preference but a necessity to ensure the plant’s health and the viability of the spores. Unlike manual collection, which risks crushing or contaminating the spores, tools provide a controlled method to isolate and gather them without disrupting the plant’s structure. For instance, fine-tipped shears allow you to snip spore-bearing structures, such as capsules or fronds, with minimal contact, preserving the plant’s integrity while maximizing yield.
The choice of tool depends on the plant species and its spore-bearing anatomy. For ferns, a small pair of pruning shears works well to cut the fiddleheads or undersides of mature fronds where spores cluster. Orchids, on the other hand, may require a scalpel or tweezers to carefully detach pollen masses without damaging the flower. Always sterilize your tools with rubbing alcohol before use to prevent introducing pathogens that could harm the plant or contaminate the spores. This step is particularly critical in humid jungle environments, where fungal and bacterial growth thrives.
Timing is as crucial as technique. Spores are typically released during specific phases of the plant’s life cycle, often in response to environmental cues like humidity or light. For example, many ferns discharge spores in the early morning, so harvesting just after dawn increases your chances of collecting mature spores. Observe the plant for signs of readiness, such as color changes or the drying of spore cases, before proceeding. Collecting too early or too late can result in spores that are either underdeveloped or already dispersed.
While efficiency is key, patience is equally important. Rushing the process can lead to accidental damage, such as tearing the plant tissue or scattering spores prematurely. Work methodically, focusing on one section at a time, and use a container with a wide opening to catch spores as they fall. A shallow dish lined with paper or a fine mesh can help prevent contamination and make it easier to transfer spores for storage or cultivation. Remember, the goal is not just to collect spores but to do so in a way that allows the plant to continue thriving, ensuring a sustainable source for future harvests.
Finally, practice makes perfect. Harvesting spores is a skill that improves with repetition and observation. Take note of how different plants respond to your techniques and adjust accordingly. For instance, if you notice a fern wilting after spore collection, try reducing the amount of tissue removed or using a sharper tool to minimize stress. By combining the right tools, timing, and care, you can master the art of spore collection, contributing to both your botanical knowledge and the preservation of jungle flora.
Effective Temperatures to Eliminate Mold Spores: A Comprehensive Guide
You may want to see also
Explore related products

Optimal Time for Collection: Gather spores at night or in shaded areas for higher yields
The timing of spore collection significantly impacts yield, and understanding the optimal conditions can make or break your harvest. Jungle spores, in particular, thrive in environments that mimic their natural habitat—humid, shaded, and cool. Collecting spores at night or in shaded areas leverages these conditions, as temperatures drop and moisture levels rise, creating an ideal environment for spore release. This simple adjustment can double or even triple your yield, making it a critical strategy for both hobbyists and professionals.
From an analytical perspective, the science behind this method lies in the behavior of fungi. Most jungle spore-producing mushrooms release their spores during cooler, more humid periods to ensure dispersal without rapid desiccation. Nighttime and shaded areas naturally provide these conditions, reducing the risk of spores drying out before collection. For instance, studies show that spore viability increases by up to 40% when collected during these optimal times compared to midday collections under direct sunlight. This data underscores the importance of aligning collection efforts with the biological rhythms of fungi.
If you’re ready to implement this strategy, follow these steps for maximum efficiency. First, identify shaded areas in your collection site, such as under dense foliage or near water sources, where humidity remains consistently high. Equip yourself with a spore print setup—a piece of aluminum foil or glass placed under the mushroom cap—and set it up just before dusk. Allow the spores to fall naturally overnight, and collect the print in the early morning before temperatures rise. For added precision, use a hygrometer to ensure humidity levels remain above 70%, as this further enhances spore release.
A comparative analysis reveals that nighttime collection outperforms daytime methods in nearly every metric. While daytime collection may seem convenient, the heat and dryness of the sun can cause spores to disperse unevenly or degrade quickly. In contrast, nighttime collection provides a controlled environment where spores settle uniformly, making them easier to gather. Additionally, shaded areas during the day offer a middle ground but still fall short of the optimal conditions achieved at night. This comparison highlights why nighttime collection is the gold standard for maximizing yield.
Finally, a practical tip to elevate your collection process: pair your nighttime efforts with a gentle misting of water around the collection area. This mimics the natural dew formation that occurs overnight in jungle environments, further encouraging spore release. However, avoid over-misting, as excessive moisture can lead to mold growth or spore clumping. With these strategies in place, you’ll not only gather more spores but also ensure their quality and viability for cultivation or study.
Understanding Spores: Mitosis or Meiosis Production Explained
You may want to see also

Storage and Preservation: Store spores in glass containers away from light to maintain viability
Glass containers are the unsung heroes of spore preservation. Unlike plastic, glass is inert, meaning it won't leach chemicals that could harm your precious jungle spores. Its non-porous surface also prevents moisture absorption, a critical factor in maintaining spore viability. Imagine storing your spores in a plastic bag—the humidity fluctuations alone could render them useless within months. Glass, however, provides a stable environment, ensuring your spores remain dormant and ready for germination when you need them.
Light, particularly UV rays, is a silent killer of spores. It can damage their DNA, reducing their ability to grow into healthy mycelium. Think of it as sunburn for spores—prolonged exposure leads to irreversible harm. To combat this, store your glass containers in a dark place, like a drawer or a cabinet. If you must keep them on a shelf, consider using opaque labels or wrapping the containers in light-blocking material. This simple step can significantly extend the lifespan of your jungle spores, ensuring they remain viable for years.
Not all glass containers are created equal. For optimal preservation, choose containers with airtight lids to prevent moisture loss and contamination. Mason jars or vials with rubber seals are excellent options. Before storing, ensure the containers are clean and dry—any residual moisture can lead to mold or bacterial growth. Label each container with the spore type, collection date, and any relevant notes. This level of organization might seem excessive, but it’s invaluable when you’re managing multiple spore samples or sharing them with fellow enthusiasts.
Temperature stability is another critical factor in spore preservation. While glass containers protect against light and moisture, they don’t regulate temperature. Store your spores in a cool, consistent environment, ideally between 4°C and 20°C (39°F and 68°F). Avoid areas prone to temperature fluctuations, like near windows or heaters. For long-term storage, consider a dedicated refrigerator or a climate-controlled cabinet. This ensures your spores remain dormant without being exposed to conditions that could trigger premature germination or degradation.
Finally, while glass containers are ideal, they’re not indestructible. Handle them with care to avoid breakage, especially if you’re storing spores in small vials. If you’re transporting spores, cushion the containers in bubble wrap or foam. Periodically inspect your storage area for signs of pests or environmental changes that could compromise your collection. With proper care, your jungle spores can remain viable for decades, ready to sprout into vibrant fungal colonies whenever you’re ready to cultivate them.
Where to Buy Milky Spore: Top Retailers and Online Sources
You may want to see also
Frequently asked questions
Jungle spores are rare, glowing fungi found in dense, tropical environments. They are valuable for crafting potions, dyes, and decorative items in many games and fantasy settings.
Jungle spores typically grow in humid, shaded areas like deep forests, caves, or near water sources. Look for bioluminescent patches on trees, rocks, or the ground.
You’ll need a sharp knife or spore-specific harvesting tool to carefully cut the spores without damaging them. Wearing gloves is recommended to avoid contamination.
Yes, jungle environments often host dangerous creatures, poisonous plants, and uneven terrain. Always be cautious and prepared with proper gear and knowledge of the area.
Yes, jungle spores can be grown in controlled environments with high humidity, indirect light, and a nutrient-rich substrate. However, it requires patience and specific conditions to succeed.